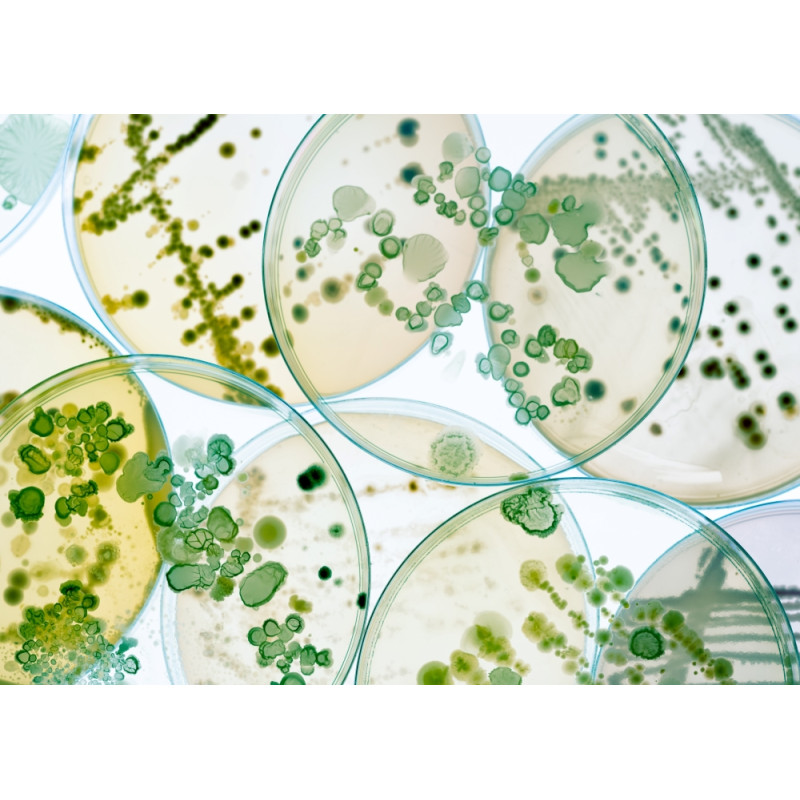
Schedline Brodzik kompozytowy Stabilsound Plus® Protos Cashemere Stone 80x170x4 cm, prostokątny, Gwarancja 15 lat

EAN: 5905805729789
Kod producenta:
3SP.P1P-80170/PK/ST-M1/PK/ST
Producent:
Schedline



Materiał Stonicryl® i technologia Stabilsound Plus® gwarantują wytrzymałość i odporność brodzika na wszelkie uderzenia, upadki czy wysoki nacisk.
Spadająca słuchawka, butelka z szamponem lub ciężkie narzędzia? Nie przejmuj się, nasze brodziki są odporne na wszelkie uderzenia.

Zadbaliśmy o to, aby powierzchnia brodzika posiadała właściwości antybakteryjne i antyalergiczne. Dodatkowo dzięki technologii Easy to Clean z łatwością zadbasz o czystość.

Możliwość indywidualnego przycięcia bryły brodzika - dopasowania do nietypowej przestrzeni prysznicowej

Montaż, z którym poradzi sobie jedna osoba.
Przy projektowaniu brodzika kierowaliśmy się tym, aby jego montaż był jak najprostszy. Poprzez wyeliminowanie konieczności używania kotw przyściennych z łatwością go zamontujesz.

Pożegnaj się z irytującymi dźwiękami i ciesz się spokojną kąpielą. Użyte przez nas materiały i komponenty skutecznie tłumią dźwięk spadającej wody podczas kąpieli.

1. Pożegnaj brud i bakterie – łatwa do czyszczenia powierzchnia (Easy to Clean) posiada także właściwości antybakteryjne (Antibac®)
2. Zapomnij o zimnie i hałasie – wypełnienie izolujące zapobiega utracie ciepła oraz zapewnia komfort pod stopami i tłumienie hałasu.
3. Wielowarstwowe wzmocnienia – materiał kompozytowy Stonicryl® wzmacnia dno i ranty brodzika.
4. Hydroszczelna warstwa ochronna – ochrona przed wilgocią i powstawaniem pleśni.
5. Stalowe wzmocnienia – zwiększają sztywność i wytrzymałość.
6. Maskownica w kolorze brodzika

Nr kat. 3SP.P1P-80170/PK/ST-M1/PK/ST
Szerokość 170cm
Długość 80cm
Promień -
Wysokość 4cm
Głębokość spad do 2%
Kształt: prostokątny
Materiał: kompozyt Stonicryl®
Kolor: kaszmirowy, struktura
Sposób montażu: w posadzce, na posadzce
Średnica odpływu: 90mm
Gwarancja: 15lat
Promocja: Brodzik + maskownica M1
Montaż Brodzików z serii Protos Cashmere Stone jest szybki i prosty, może wykonać go samodzielnie jedna osoba. Brodzik można zamontować bezprogowo (rozwiązanie to docenią wszyscy użytkownicy, a szczególnie seniorzy lub osoby z ograniczeniami ruchowymi). Powierzchnia o kaszmirowej kamienistej strukturze (RAL 9001; klasa antypoślizgowa „A” (wg DIN 16165 – zał A.)) zapewnia komfort użytkowania i zmniejsza ryzyko upadków spowodowanych poślizgnięciem. Seria ta idealnie wpasuje się do każdej przestrzeni łazienkowej ponieważ istnieje możliwość docięcia Brodzika do odpowiedniego wymiaru.

Wybierając produkty Schedline, stawiasz na rozwiązania, które łączą trwałość, komfort i bezpieczeństwo w jednym. To wyposażenie stworzone z myślą o codziennym użytkowaniu – przez dorosłych, dzieci i każdego, kto ceni bezproblemową kąpiel.
Nasze brodziki, wanny i odpływy liniowe powstają w oparciu o europejskie technologie Stabilsound Plus® i Standard Plus®– wyjątkowo stabilne, odporne i sprawdzone w tysiącach łazienek. Dzięki temu montaż jest prosty, użytkowanie wygodne, a konstrukcja zachowuje swoją formę przez lata.
Schedline® oferuje także gotowe systemy do zabudowy pod płytkę, które zapewniają idealne podparcie, bezpieczeństwo użytkowania i szybkość montażu wanien w połączeniu z ich idealną stabilnością.
Produkty tworzymy w Polsce, opierając się na blisko 45 latach doświadczenia. Każdy element został zaprojektowany po to, by Twoja łazienka była miejscem komfortowej i bezpiecznej kąpieli przez długi, długi czas.

Kolor: Cashmere Stone (kaszmirowy kamień)
